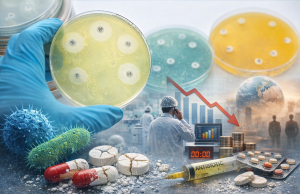

Etiket: Halk Sağlığı
Bağışıklıktan Kaçma Potansiyeli Olan Yeni SARS-CoV-2 Varyantı 23 Ülkede Tespit Edildi
Yeni SARS-CoV-2 varyantı BA.3.2
Obeziteyle Mücadelede Hekim – Eczacı İş Birliği: HOBİSAD’dan Kritik Uyarı!
Sosyal Medyadaki Zayıflama Vaatlerine Bilimsel FrenHormon Bilim ve Sağlık Derneği (HOBİSAD) tarafından düzenlenen “Bilim Köprüleri – Dengenin Dinamiği” çalıştayının sonuç raporu, obezite tedavisinde giderek...
Avrupa’da Tüberkülozla Mücadelede Alarm: Vakaların Beşte Biri Tespit Edilemiyor, İlaç Direnci...
Dünya Tüberküloz Günü, yalnızca bir farkındalık günü değil; aynı zamanda küresel sağlık sistemlerinin eksiklerini gözler önüne seren kritik bir hatırlatmadır. DSÖ ve ECDC’nin yayımladığı...
Zona Aşısının Kalp Hastalığı Olan Yaşlılarda Kalp Krizi Riskini Yarıya İndirdiği...
Yeni araştırmalar, zona (herpes zoster) aşısının yalnızca enfeksiyona karşı koruma sağlamakla kalmadığını, aynı zamanda kalp hastalığı olan yaşlı bireylerde kalp krizi riskini önemli ölçüde...
Ketamin Tehlikesi: Tıbbi Gereklilikten Yasadışı Pazara
Ketamin insan ve veteriner hekimliğinde anestezik ve analjezik olarak uzun süredir yerleşik bir role sahip sentetik bir maddedir. 1960’larda fensiklidine (PCP) daha güvenli bir...
İlaç Endüstrisi Antimikrobiyal Dirence Yetişemiyor
Antimikrobiyal direnç (AMR), modern tıbbın en büyük tehditlerinden biri haline geldi. 2026 Benchmark raporu, ilaç endüstrisinin bu tehdide karşı verdiği yanıtın yetersiz olduğunu açıkça...